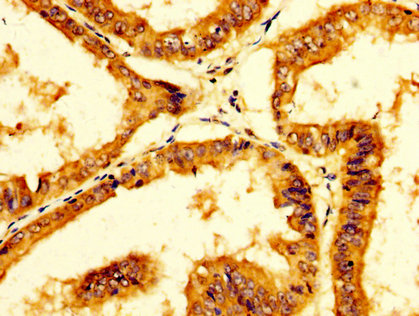

PPA1 Antibody
-
中文名稱:PPA1兔多克隆抗體
-
貨號(hào):CSB-PA614884LA01HU
-
規(guī)格:¥440
-
圖片:
-
IHC image of CSB-PA614884LA01HU diluted at 1:200 and staining in paraffin-embedded human lung tissue performed on a Leica BondTM system. After dewaxing and hydration, antigen retrieval was mediated by high pressure in a citrate buffer (pH 6.0). Section was blocked with 10% normal goat serum 30min at RT. Then primary antibody (1% BSA) was incubated at 4°C overnight. The primary is detected by a biotinylated secondary antibody and visualized using an HRP conjugated SP system.
-
IHC image of CSB-PA614884LA01HU diluted at 1:200 and staining in paraffin-embedded human endometrial cancer performed on a Leica BondTM system. After dewaxing and hydration, antigen retrieval was mediated by high pressure in a citrate buffer (pH 6.0). Section was blocked with 10% normal goat serum 30min at RT. Then primary antibody (1% BSA) was incubated at 4°C overnight. The primary is detected by a biotinylated secondary antibody and visualized using an HRP conjugated SP system.
-
Immunofluorescence staining of Hela cells with CSB-PA614884LA01HU at 1:66, counter-stained with DAPI. The cells were fixed in 4% formaldehyde, permeabilized using 0.2% Triton X-100 and blocked in 10% normal Goat Serum. The cells were then incubated with the antibody overnight at 4°C. The secondary antibody was Alexa Fluor 488-congugated AffiniPure Goat Anti-Rabbit IgG(H+L).
-
-
其他:
產(chǎn)品詳情
-
產(chǎn)品名稱:Rabbit anti-Homo sapiens (Human) PPA1 Polyclonal antibody
-
Uniprot No.:
-
基因名:
-
別名:cytosolic inorganic pyrophosphatase antibody; diphosphate phosphohydrolase antibody; inorganic diphosphatase antibody; inorganic pyrophosphatase 1 antibody; Inorganic pyrophosphatase antibody; IOPPP antibody; IPYR_HUMAN antibody; PP antibody; PP1 antibody; PPA1 antibody; PPase antibody; Pyp antibody; pyrophosphatase, inorganic, 1 antibody; Pyrophosphate phospho hydrolase antibody; Pyrophosphate phospho-hydrolase antibody; SID6-8061 antibody
-
宿主:Rabbit
-
反應(yīng)種屬:Human
-
免疫原:Recombinant Human Inorganic pyrophosphatase protein (59-173AA)
-
免疫原種屬:Homo sapiens (Human)
-
標(biāo)記方式:Non-conjugated
本頁(yè)面中的產(chǎn)品,PPA1 Antibody (CSB-PA614884LA01HU),的標(biāo)記方式是Non-conjugated。對(duì)于PPA1 Antibody,我們還提供其他標(biāo)記。見(jiàn)下表:
-
克隆類型:Polyclonal
-
抗體亞型:IgG
-
純化方式:>95%, Protein G purified
-
濃度:It differs from different batches. Please contact us to confirm it.
-
保存緩沖液:Preservative: 0.03% Proclin 300
Constituents: 50% Glycerol, 0.01M PBS, pH 7.4 -
產(chǎn)品提供形式:Liquid
-
應(yīng)用范圍:ELISA, IHC, IF
-
推薦稀釋比:
Application Recommended Dilution IHC 1:200-1:500 IF 1:50-1:200 -
Protocols:
-
儲(chǔ)存條件:Upon receipt, store at -20°C or -80°C. Avoid repeated freeze.
-
貨期:Basically, we can dispatch the products out in 1-3 working days after receiving your orders. Delivery time maybe differs from different purchasing way or location, please kindly consult your local distributors for specific delivery time.
-
用途:For Research Use Only. Not for use in diagnostic or therapeutic procedures.
相關(guān)產(chǎn)品
靶點(diǎn)詳情
-
基因功能參考文獻(xiàn):
- The p37 controls cortical NuMA levels via the phosphatase PP1 and its regulatory subunit Repo-Man, but it acts independently of Galphai, the kinase Aurora A, and the phosphatase PP2A. PMID: 29222185
- Proteomic profiling identifies the inorganic pyrophosphatase (PPA1) protein as a potential biomarker of metastasis in laryngeal squamous cell carcinoma. PMID: 26948660
- Results show that PPA1 expression is significantly higher in many tumors, especially those of lung and ovarian origin, which suggests that PPA1 plays an important role in carcinogenesis and in the development of some tumors. PMID: 27666431
- PPA1 serves as a potential prognostic biomarker for patients with Ovarian serous carcinoma. PMID: 28202851
- Thus, the Ska complex, specifically the Ska1 C-terminal domain, recruits PP1 to kinetochores to oppose spindle checkpoint signaling kinases and promote anaphase onset. PMID: 26981768
- PPA1 may serve as a potential biomarker of poor prognosis in patients with gastric cancer PMID: 26722435
- PP-1 and Akt have roles in AR-v7 protein expression and activities when AR is functionally blocked PMID: 26378044
- The Newcastle disease virus-induced translation shutoff at late infection times was attributed to sustaining phosphorylation of eIF2a, which is mediated by continual activation of PKR and degradation of PP1. PMID: 26869028
- The human PP1 interaction with the measles V protein is mediated by a conserved PP1-binding motif in the C-terminal region of the V protein. PMID: 25011105
- Measles virus binding to DC-SIGN leads to inhibition of PP1 phosphatase activity and hence inhibition of RIG-I and Mda5 dephosphorylation. PMID: 25011106
- Results identify PP1 as a novel regulator of Cl(-)-HCO3(-) anion exchangers activity which, in concert with CFTR, coordinates events at both apical and basolateral membranes, crucial for efficient HCO3(-) secretion from Calu-3 cells. PMID: 23215877
- PPP1R42 regulation of PP1 function in centrosome separation. PMID: 23718219
- Pyrophosphatase overexpression is associated with invasion, metastasis and recurrence in gastric cancer PMID: 22797819
- PP1gamma is the major histone H3 phosphatase acting on the mitotically phosphorylated residues H3T3ph, H3S10ph, H3T11ph, and H3S28ph. PMID: 21514157
- IRBIT opposes the effects of WNKs and SPAK by recruiting PP1 to the complex to dephosphorylate CFTR and NBCe1-B, restoring their cell surface expression, in addition to stimulating their activities PMID: 21317537
- Data are consistent with the postsynaptic gephyrin scaffold acting as a platform for protein phosphatase 1 (PP1), which regulates gephyrin cluster size by dephosphorylation of gephyrin- or cytoskeleton-associated proteins. PMID: 20206270
- Neither human hexokinase-1 nor human inorganic pyrophosphatase expression segregated concordantly with human cytoplasmic glutamic-oxaloacetic transaminase expression. PMID: 17494625
顯示更多
收起更多
-
亞細(xì)胞定位:Cytoplasm.
-
蛋白家族:PPase family
-
組織特異性:Expressed ubiquitously.
-
數(shù)據(jù)庫(kù)鏈接:
Most popular with customers
-
-
YWHAB Recombinant Monoclonal Antibody
Applications: ELISA, WB, IHC, IF, FC
Species Reactivity: Human, Mouse, Rat
-
Phospho-YAP1 (S127) Recombinant Monoclonal Antibody
Applications: ELISA, WB, IHC
Species Reactivity: Human
-
-
-
-
-